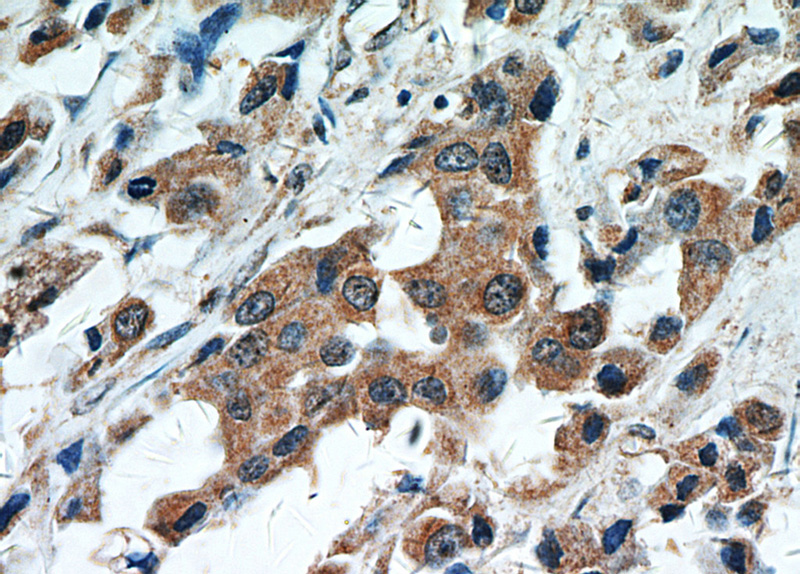
Immunohistochemical of paraffin-embedded human breast cancer using Catalog No:115685(STAT2 antibody) at dilution of 1:50 (under 40x lens)

-
Product Name
STAT2 antibody
- Documents
-
Description
STAT2 Rabbit Polyclonal antibody. Positive IP detected in HeLa cells. Positive WB detected in HeLa cells, HT-1080 cells, K-562 cells. Positive IHC detected in human breast cancer tissue, human lung cancer tissue. Observed molecular weight by Western-blot: 113 kDa
-
Tested applications
ELISA, WB, IHC, IP
-
Species reactivity
Human,Mouse,Rat; other species not tested.
-
Alternative names
ISGF 3 antibody; P113 antibody; STAT113 antibody; STAT2 antibody
-
Isotype
Rabbit IgG
-
Preparation
This antibody was obtained by immunization of STAT2 recombinant protein (Accession Number: NM_005419). Purification method: Antigen affinity purified.
-
Clonality
Polyclonal
-
Formulation
PBS with 0.02% sodium azide and 50% glycerol pH 7.3.
-
Storage instructions
Store at -20℃. DO NOT ALIQUOT
-
Applications
Recommended Dilution:
WB: 1:500-1:5000
IP: 1:200-1:2000
IHC: 1:20-1:200
-
Validations

HeLa cells were subjected to SDS PAGE followed by western blot with Catalog No:115685(STAT2 antibody) at dilution of 1:500

Immunohistochemical of paraffin-embedded human breast cancer using Catalog No:115685(STAT2 antibody) at dilution of 1:50 (under 10x lens)
Immunohistochemical of paraffin-embedded human breast cancer using Catalog No:115685(STAT2 antibody) at dilution of 1:50 (under 40x lens)

IP Result of anti-STAT2 (IP:Catalog No:115685, 4ug; Detection:Catalog No:115685 1:500) with HeLa cells lysate 2800ug.
-
Background
STAT2, also named as p113, belongs to the transcription factor STAT family. It is a signal transducer and activator of transcription that mediates signaling by type I IFNs (IFN-alpha and IFN-beta). Following type I IFN binding to cell surface receptors, Jak kinases (TYK2 and JAK1) are activated, leading to tyrosine phosphorylation of STAT1 and STAT2. The phosphorylated STATs dimerize and associate with ISGF3G/IRF-9 to form a complex termed ISGF3 transcription factor, that enters the nucleus. ISGF3 binds to the IFN stimulated response element (ISRE) to activate the transcription of interferon stimulated genes, which drive the cell in an antiviral state. It also interacts with CRSP2, CRSP6, Simian virus 5 protein V, rabies virus phosphoprotein, IFNAR1 and IFNAR2. Its interaction with dengue virus NS5 inhibits the phosphorylation of STAT2, and, when all viral proteins are present (polyprotein), STAT2 is targeted for degradation. This antibody is a rabbit polyclonal antibody raised against residues near the C terminus of human STAT2.
Related Products / Services
Please note: All products are "FOR RESEARCH USE ONLY AND ARE NOT INTENDED FOR DIAGNOSTIC OR THERAPEUTIC USE"
